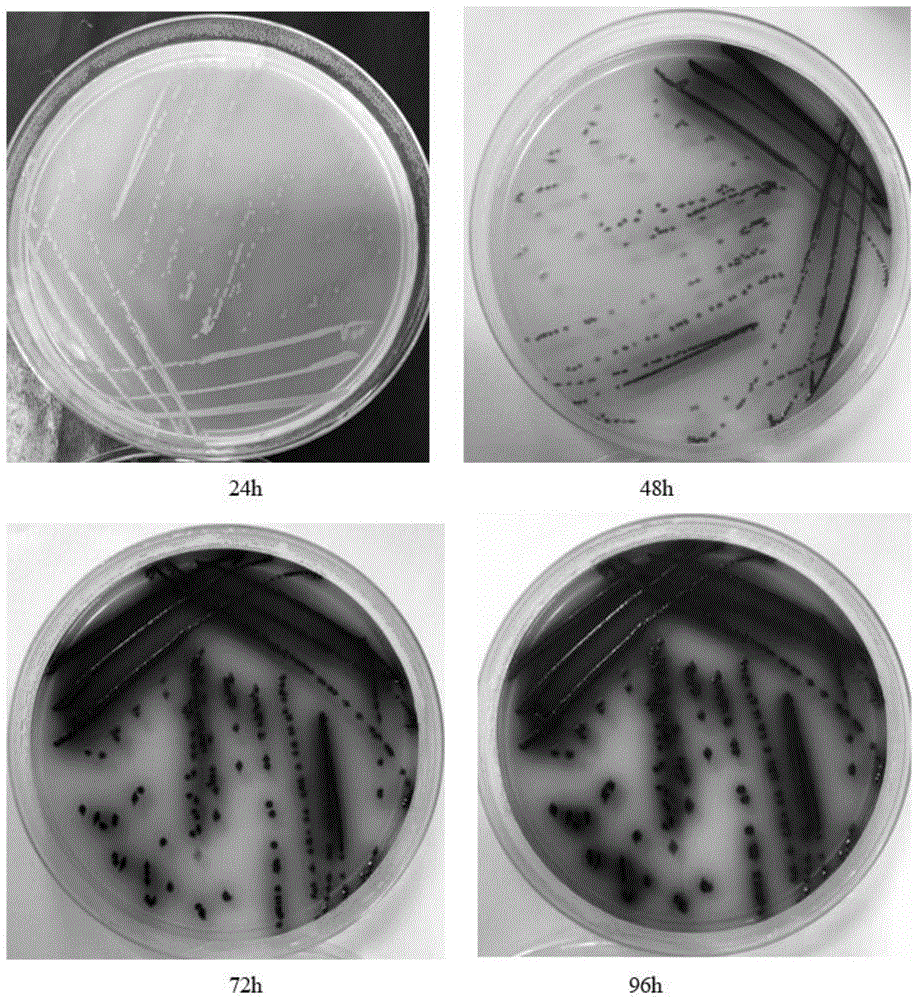
cn111996154a_枯草芽孢杆菌黑色变种培养基及其制备方法与应用在审

枯草芽孢杆菌手绘

枯草芽孢杆菌是大自然的清洁工,生长在土壤表面,分解自然界中的有机
图片尺寸1080x660
沈亚恒的手绘真菌图作品.jpg
图片尺寸4032x3024
如何测定培养液中真菌的数目?
图片尺寸199x196
5 枯草芽孢杆菌(复方新诺明 敏感):菌体变化不明显,仅着色不良或染色
图片尺寸600x800
微生物芽孢菌世界! - 抖音
图片尺寸859x839
10.10 实验一 细菌的简单染色和革兰氏染色
图片尺寸831x1098
枯草芽孢杆菌-菌号atcc6633
图片尺寸850x850
芽孢杆菌图标
图片尺寸256x256
医生打病菌的简笔画
图片尺寸209x211
革兰氏染色的基本原理及方法 - 简书
图片尺寸3120x4160
一种枯草芽孢杆菌菌株及其应用制造技术
图片尺寸1000x732
枯草芽孢杆菌图片
图片尺寸300x300
枯草芽孢杆菌
图片尺寸500x562
枯草芽孢杆菌制作方法
图片尺寸640x632
一种枯草芽孢杆菌b51及其应用制造技术
图片尺寸1000x752
cn111996154a_枯草芽孢杆菌黑色变种培养基及其制备方法与应用在审
图片尺寸918x1000
河南君安(图)|枯草芽孢杆菌 论文|枯草芽孢杆菌
图片尺寸650x512
3 枯草芽孢杆菌(亚胺培南 敏感):与正常形态相比,菌体大小变化不大,但
图片尺寸600x800
神奇的枯草芽孢杆菌
图片尺寸640x840
兽医图片枯草杆菌芽孢
图片尺寸500x336

.gif)